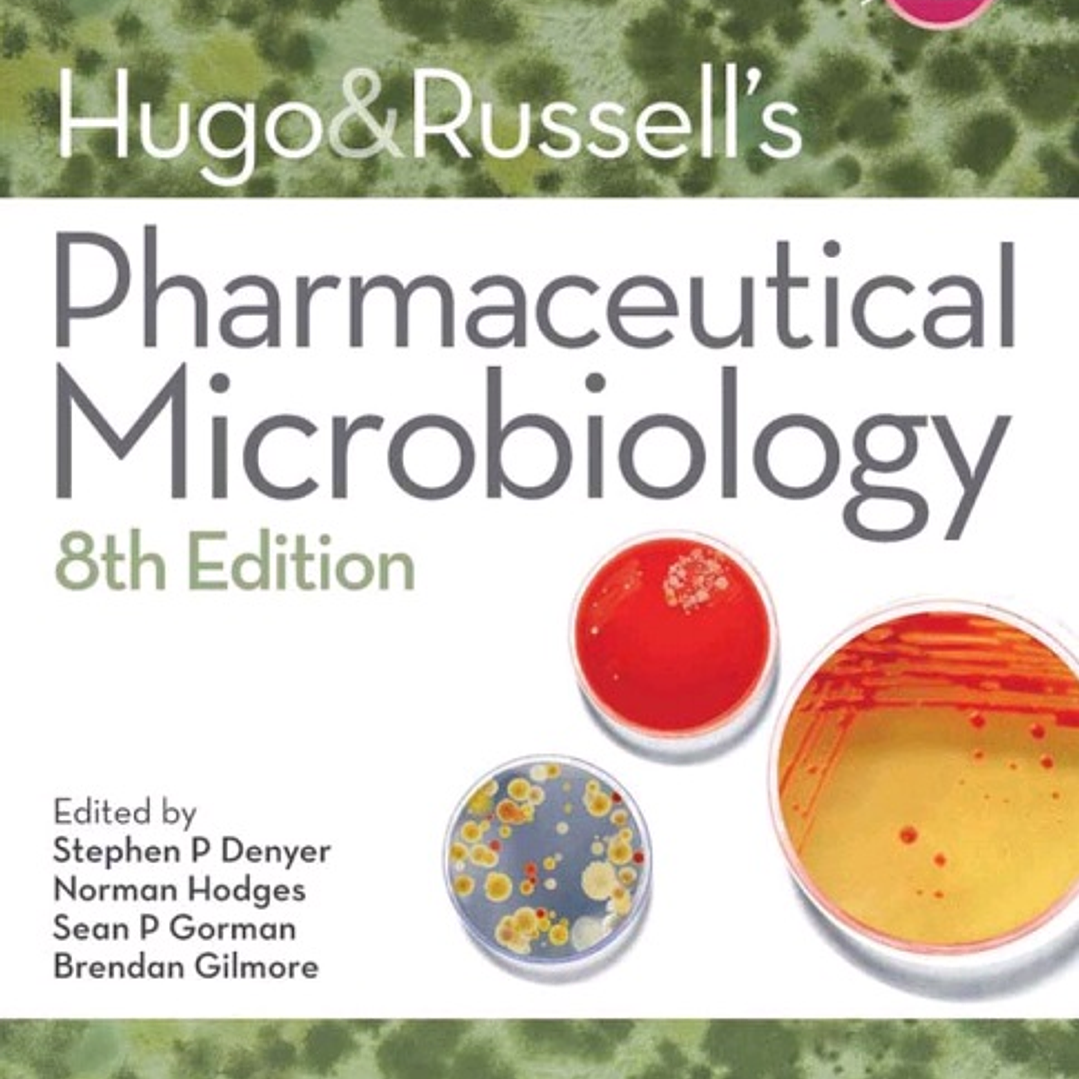

|
Hugo and Russell's Pharmaceutical Microbiology
Description
8th Edition
by Stephen P. Denyer (Editor), Norman A. Hodges (Editor), Sean P. Gorman (Editor), Brendan F. Gilmore (Editor)
Pharmaceutical microbiology has a bearing on all aspects of pharmacy, from the manufacture and quality control of pharmaceutical products through to an understanding of the mode of action of antibiotics.
Fully revised and restructured, drawing on the contributions of subject experts, and including material relevant to the European curricula in pharmacy, the eighth edition covers:
- biology of micro-organisms
- pathogens and host response
- prescribing therapeutics
- contamination and infection control
- pharmaceutical production
- current trends and new directions
Hugo and Russell’s Pharmaceutical Microbiology, a standard text for Schools of Pharmacy for seven editions, continues to be a user-friendly and authoritative guide for both students and practitioners of pharmacy and pharmaceutical microbiology.
Details
Year:
2011
Pages:
525
Language:
English
Format:
PDF
Size:
4 MB
ISBN-10:
1444330632
ISBN-13:
978-1444330632
ASIN:
B006FLW2AE